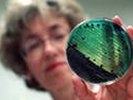
ПНТЗ провел мониторинг состояния воздуха

ПНТЗ провел мониторинг состояния воздуха
Санитарно-экологическая лаборатория ПНТЗ провела очередной мониторинг состояния атмосферного воздуха за границей санитарно-защитной зоны завода. Пробы отбирались в Трудпоселке и поселке Талица с 23 по 25 марта.
Санитарно-экологическая лаборатория ПНТЗ провела очередной мониторинг состояния атмосферного воздуха за границей санитарно-защитной зоны завода. Пробы отбирались в Трудпоселке и поселке Талица с 23 по 25 марта.
По итогам замеров характерные для промышленных предприятий оксид углерода находится на уровне 2,3 мг/м3 при ПДК 5 мг/м3, диоксид азота – на уровне 0,027 мг/м3 при ПДК 0,2 мг/м3.
В ходе исследования в воздухе также обнаружен формальдегид – 0,002 мг/м3 при ПДК 0,035, взвешенные вещества (пыль) – 0,31 мг/м3 при разрешенных 0,5 мг/м3, серная кислота – 0,05 мг/м3 при ПДК 0,3 мг/м3, диоксид серы – 0,03 мг/м3 при ПДК 0,5 мг/м3, гидрофторид – 0,0025 мг/м3.
- Замеры воздуха не определяют источник загрязнения, а только фиксируют наличие тех или иных веществ в воздухе, - комментирует начальник службы охраны окружающей среды ПНТЗ Александр Мишарин. - Например, оксид углерода выделяется при сжигании природного газа, на котором работают все заводы Первоуральска. Диоксид азота и взвешенные вещества выделяет транспорт, который на сегодняшний момент является главным фактором загрязнения городской атмосферы, – Кроме того, соединения серы характерны для многих промышленных предприятий Первоуральска и Ревды и тех же дизельных двигателей. В целом, превышений ПДК по основной группе вредных для окружающей среды веществ в ходе исследований не обнаружено.
Газопылеулавливающие установки ПНТЗ работают в штатном режиме. Стационарный датчик, установленный на газоочистке электросталеплавильного комплекса «Железный Озон 32», в течение недели фиксировал показатели концентрации пыли в воздухе на уровне 0,3-2 мг/м3 при допустимом уровне в 50 мг/м3 в соответствии с Российским законодательством и европейскими нормами ПДК в 10 мг/м3.
Аварийных и залповых сбросов загрязняющих средств в водоемы Первоуральска не производилось.
Более 3500 тонн отходов производства переданы на использование ЗАО «Экорус-Первоуральск», ЗАО «Мета-Екатеринбург», транспортированы ООО «Горкомхоз» (ТБО).
@ www.pervo.ru
